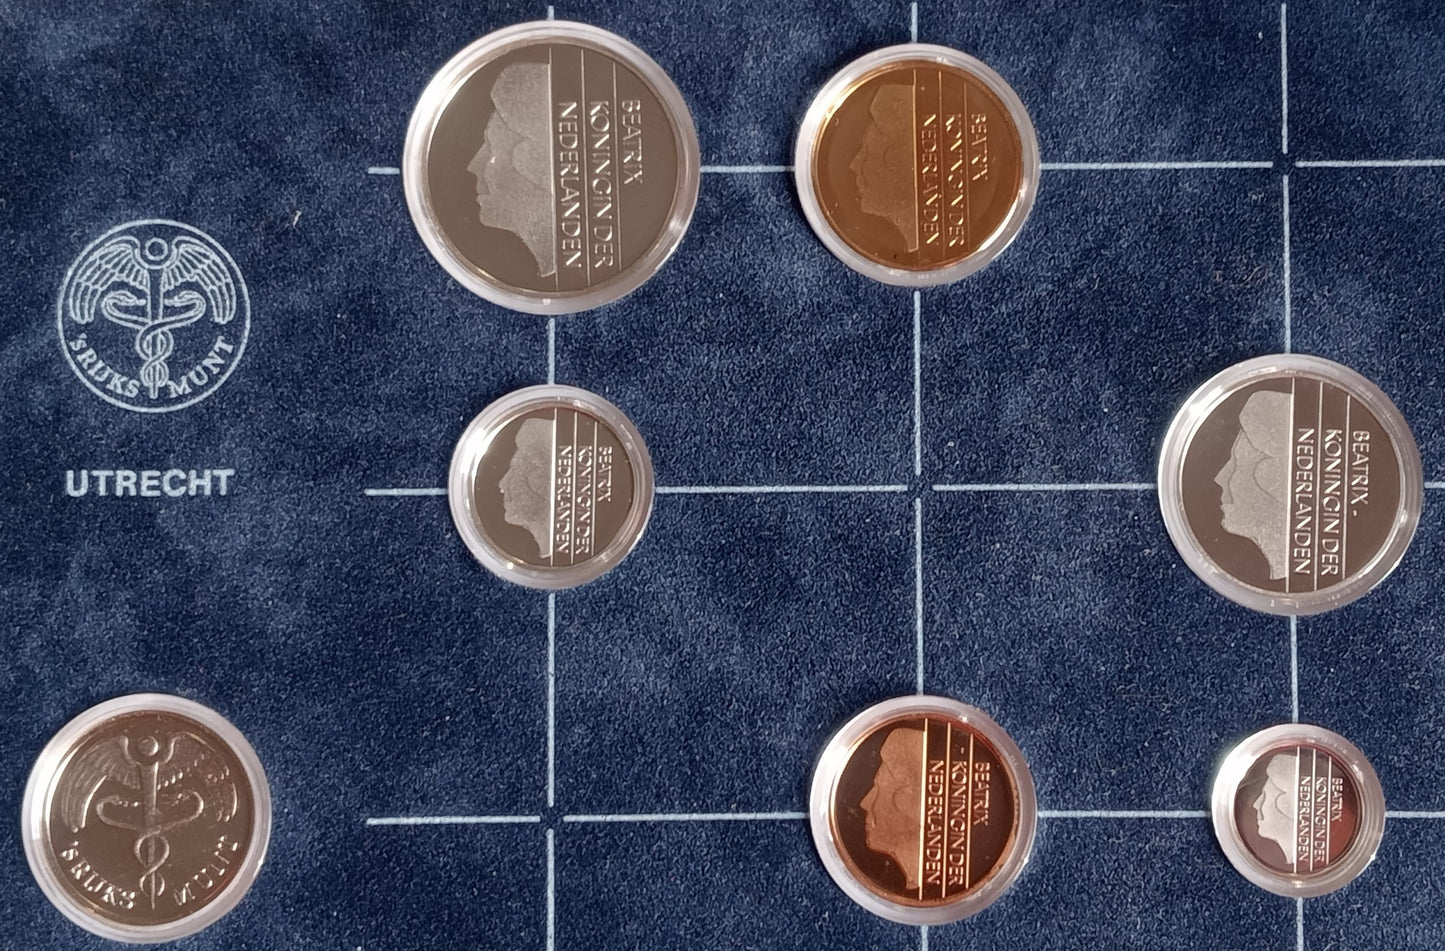
1989 Różne Guldeny Zestaw PROOF

1989 Różne Guldeny Zestaw PROOF
1989 Różne Guldeny Zestaw PROOF
Cena regularna
48,00 zł PLN
Cena regularna
Cena promocyjna
48,00 zł PLN
Z wliczonymi podatkami.
Koszt wysyłki obliczony przy realizacji zakupu.
Ilość
Nie można załadować gotowości do odbioru
Zestaw 6 monet + medal:
km202 5 centów 3,5 gr. Brąz 21,0 mm Zwykły
km203 10 centów 1,5 gr. Nikiel 15,0 mm, ząbkowany
km204 25 centów 3,0 gr. Nikiel 19,0 mm, ząbkowany
km205 1 Gulden 6,0 gr. Nikiel 25,0 mm Gładki z mottem incuse
km206 2½ Gulden 10,0 gr. Nikiel 29,0 mm Gładki z mottem incuse
km210 5 Guldenów 9,25 gr. Brąz platerowany niklem 23,5 mm Stroik z mottem incuse
medal: Flevoland 5,5 gr. Srebro 925/1000 23,0 mm Gładkie
Share